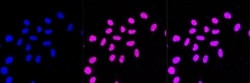
Invitrogen SF3B3 Recombinant Rabbit Monoclonal Antibody (23GB2260), Invitrogen

missing translation for 'onlineSavingsMsg'
Learn More
Learn More
Invitrogen™ SF3B3 Recombinant Rabbit Monoclonal Antibody (23GB2260), Invitrogen™
Rabbit Recombinant Monoclonal Antibody
Brand: Invitrogen™ MA552489
This item is not returnable.
View return policy
Description
This gene encodes subunit 3 of the splicing factor 3b protein complex. Splicing factor 3b, together with splicing factor 3a and a 12S RNA unit, forms the U2 small nuclear ribonucleoproteins complex transcription coactivator-HAT complex, and the TFTC -containing complex). These complexes may function in chromatin modification, transcription, splicing, and DNA repair.
Specifications
| SF3B3 | |
| Recombinant Monoclonal | |
| Unconjugated | |
| SF3B3 | |
| 1810061H24Rik; 5730409A01Rik; AA409318; D8Ertd633e; Kiaa0017; mKIAA0017; pre-mRNA splicing factor SF3b, 130 kDa subunit; pre-mRNA-splicing factor SF3b 130 kDa subunit; RSE1; SAP 130; SAP130; SF3b130; SF3B3; Spliceosome-associated protein 130; splicing factor 3b subunit 3; splicing factor 3b, subunit 3; STAF130 | |
| Rabbit | |
| Affinity chromatography | |
| RUO | |
| 101943, 23450, 292019 | |
| -20°C | |
| Liquid |
| Flow Cytometry, Western Blot, Immunocytochemistry | |
| 23GB2260 | |
| PBS with 50% glycerol and 0.02% sodium azide; pH 7.4 | |
| Q15393, Q921M3 | |
| SF3B3 | |
| A synthetic peptide of human CXCR7 (1150-1217AA). | |
| 20 μL | |
| Primary | |
| Human, Mouse, Rat | |
| Antibody | |
| IgG |
Product Content Correction
Your input is important to us. Please complete this form to provide feedback related to the content on this product.
Product Title
Spot an opportunity for improvement?Share a Content Correction